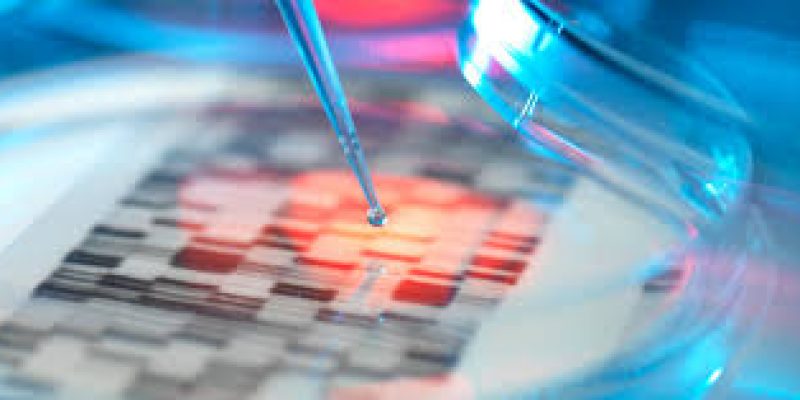
DST developed antiviral nano-coatings for making triple layer medical masks and N-95 respirator

Astronomers have found 19 asteroids that once belonged to a distant star system have been found orbiting the Sun between Jupiter and Neptune. The asteroids have been circling the sun for more than 4.5 billion years, since the very inception of the solar system. Daily Current Affairs Quiz 2020 ...
READ MORE +